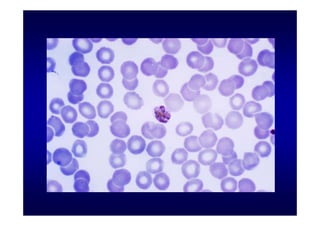

Este documento presenta una introducción a la parasitología médica. Explica que la parasitología médica estudia las relaciones entre parásitos y sus hospederos humanos, y la importancia de comprender estas relaciones debido a que los seres humanos son hospederos de cientos de especies parásitas. También proporciona una lista de los principales parásitos médicamente importantes como protozoos, helmintos y artrópodos, y las enfermedades que causan. Finalmente, resume brevemente la historia de la paras